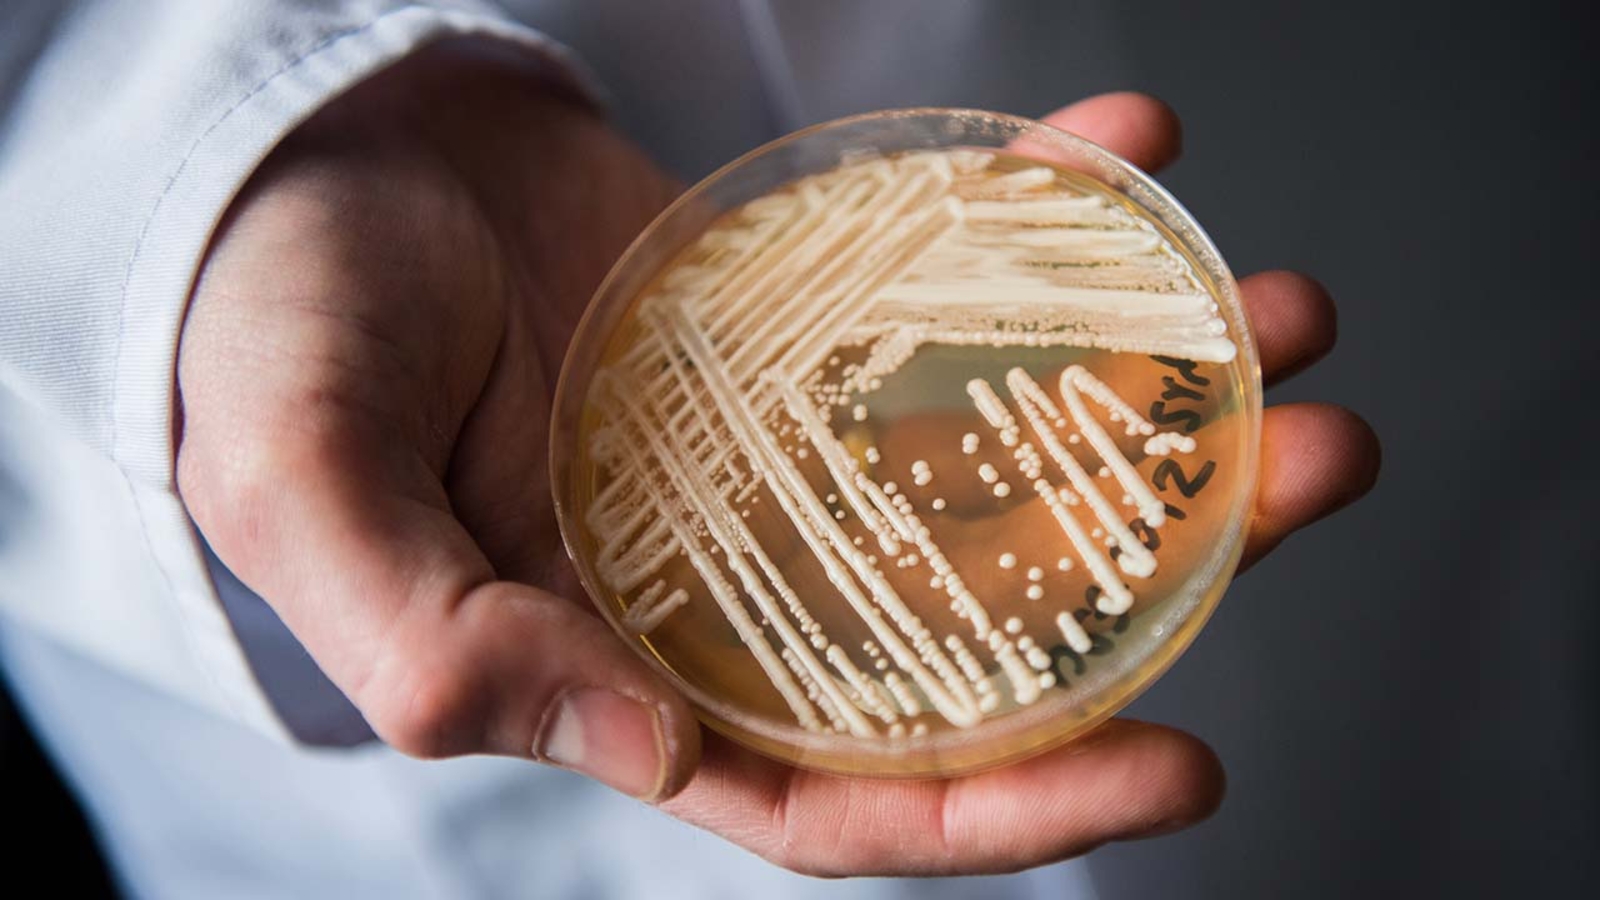

Clinical cases of Candida auris, an emerging fungus considered an urgent threat, nearly doubled in 2021, according to new data from the US Centers for Disease Control and Prevention.
There was also a tripling of the number of cases resistant to echinocandins, the first-line treatment for Candida auris infections.
The research, published Monday in the Annals of Internal Medicine, evaluated cases of Candida auris reported to the CDC from 2016 -- the year in which cases were first reported in the US -- to 2021.
The study authors found that clinical cases increased each year, rising from 53 in 2016 to 330 in 2018 and then skyrocketing from 476 in 2019 to 1,471 in 2021.
Cases of Candida auris also expanded geographically. Although it was initially confined mostly to the New York City and Chicago areas, Candida auris is now present in more than half of US states. Between 2019 and 2021, 17 states identified their first cases.
The CDC has called Candida auris an "urgent threat" because it is often multidrug-resistant, easily spreads through health care facilities and can cause deadly disease. It is also resistant to some common disinfectants and can be carried on people's skin without causing symptoms, facilitating its spread to others.
The researchers wrote that the timing of this increased spread suggests that it may have been exacerbated by "pandemic-related strain on the health care and public health system."
"The rapid rise and geographic spread of cases is concerning and emphasizes the need for continued surveillance, expanded lab capacity, quicker diagnostic tests, and adherence to proven infection prevention and control," CDC epidemiologist Dr. Meghan Lyman, lead author of the study, said in a news release.
The spread of Candida auris in the US comes amid growing concerns about health-threatening fungi.
Late last year, the World Health Organization released its first list of "fungal priority pathogens," including Candida auris.
"Fungal pathogens are a major threat to public health as they are becoming increasingly common and resistant to treatment with only four classes of antifungal medicines currently available," WHO says.
The organization says the expanding incidence and geographic range of fungal disease may be due to global warming and the increase of international trade and travel.
Candida auris itself first appeared as four strains on four continents between 2009 and 2015. All four strains have now been identified in the US, probably introduced through international travel, the CDC says.
Transmission of the fungus within the US is largely driven by "poor general infection prevention and control practices in healthcare facilities," the authors of the new study say. Most spread happens in post-acute care facilities and ventilator-capable skilled-nursing facilities.
Dr. Scott Roberts, an infectious-disease specialist at the Yale School of Medicine who was not involved with the new study, warns that the increased prevalence and drug resistance of Candida auris is a serious health threat.
"I think this problem is not going to go away. I think it's really only going to increase over time," he said.
Unlike other fungi that are typically acquired from the environment, Candida auris is easily spread from person to person, Roberts said.
"Once it sets up shop, in a nursing home for example, it's almost impossible to eradicate," he said. "Once it's on patients too, it can kind of just be colonized for years, if not their life."
Public health officials have enhanced surveillance efforts to detect Candida auris, including testing for the fungus on the bodies of asymptomatic people. According to the new study, screening cases tripled from 2020 to 2021, for a total of 4,041.
Healthy people don't usually get sick from Candida auris, according to the CDC. Rather, it's more likely to affect people who have serious medical problems and require long stays in health care facilities, people with weakened immune systems and people with medical devices going into their bodies, such as breathing tubes or catheters. Screening for Candida auris can help protect people at increased risk of serious infection.
The-CNN-Wire & 2023 Cable News Network, Inc., a Warner Bros. Discovery Company. All rights reserved.